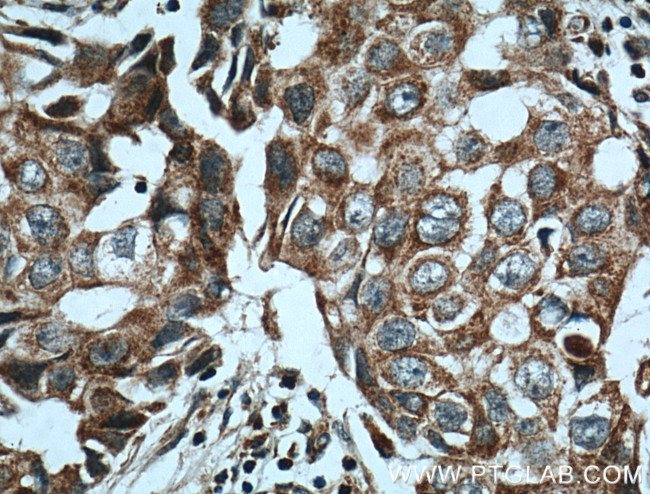
NCKIPSD Antibody in Immunohistochemistry (Paraffin) (IHC (P))

Search
Proteintech
NCKIPSD Polyclonal Antibody
{{$productOrderCtrl.translations['antibody.pdp.commerceCard.promotion.promotions']}}
{{$productOrderCtrl.translations['antibody.pdp.commerceCard.promotion.viewpromo']}}
{{$productOrderCtrl.translations['antibody.pdp.commerceCard.promotion.promocode']}}: {{promo.promoCode}} {{promo.promoTitle}} {{promo.promoDescription}}. {{$productOrderCtrl.translations['antibody.pdp.commerceCard.promotion.learnmore']}}
产品信息
11367-1-AP
种属反应
已发表种属
宿主/亚型
分类
类型
抗原
偶联物
形式
浓度
规格
纯化类型
保存液
内含物
保存条件
运输条件
产品详细信息
Immunogen sequence: GQVCHDQQR LEVIFADLAR RKDDAQQRSW ALYEDEGVIR CYLEELLHIL TDADPEVCKK MCKRNEFESV LALVAYYQME HRASLRLLLL KCFGAMCSLD AAIISTLVSS VLPVELARDM QTDTQDHQKL CYSALILAMV FSMGEAVPYA HYEHLGTPFA QFLLNIVEDG LPLDTTEQLP DLCVNLLLAL NLHLPAADQN VIMAALSKHA NVKIFSEKLL LLLNRGDDPV RIFKHEPQPP HSVLKFLQDV FGSPATAAIF YHTDMMALID ITVRHIADLS PGDKLRMEYL SLMHAIVRTT PYLQHRHRLP DLQAILRRIL NEEETSPQCQ MDRMIVREMC KEFLVLGEAP S (366-715 aa encoded by BC016052)
靶标信息
The protein encoded by this gene is localized exclusively in the cell nucleus. It plays a role in signal transduction, and may function in the maintenance of sarcomeres and in the assembly of myofibrils into sarcomeres. It also plays an important role in stress fiber formation. The gene is involved in therapy-related leukemia by a chromosomal translocation t(3;11)(p21;q23) that involves this gene and the myeloid/lymphoid leukemia gene. Alternative splicing occurs in this locus and two transcript variants encoding distinct isoforms have been identified.
仅用于科研。不用于诊断过程。未经明确授权不得转售。
生物信息学
蛋白别名: 54 kDa VacA-interacting protein; 54 kDa vimentin-interacting protein; 90 kDa N-WASP-interacting protein; 90 kDa SH3 protein interacting with Nck; adaptor protein; AF3p21; dia interacting protein; Dia-interacting protein 1; diaphanous protein interacting protein; Diaphanous protein-interacting protein; DIP-1; mDia interacting protein-1; MGC23891; N-WASP-binding protein; NCK-interacting protein with SH3 domain; SH3 adapter protein SPIN90; SH3 protein interacting with Nck, 90 kDa; unnamed protein product; VIP54; WASP-interacting SH3-domain protein; WISH; WISH-B; Wiskott-Aldrich syndrome homolog binding protein; Wiskott-Aldrich syndrome protein-binding protein; wiskott-Aldrich syndrome protein-binding protein WISH; Wiskott-Aldrich syndrome protein-interacting protein
基因别名: AF3P21; DIP; DIP1; NCKIPSD; ORF1; SPIN90; VIP54; Wasbp; WASLBP; WISH
UniProt ID: (Human) Q9NZQ3, (Mouse) Q9ESJ4
Entrez Gene ID: (Human) 51517, (Mouse) 80987